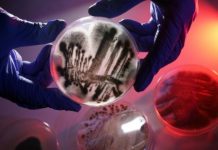
Research: Research team clarifies the mechanism of gliotoxin, a mycotoxin from the fungus Aspergillus fumigatus —

Research: Marine snail venom could improve insulin for diabetic patients —
Although moderately mobile, marine cone snails have perfected several strategies to capture prey. Some fish-hunting species release venom into the surrounding water. Within...
Research: New deep sea animal discoveries warrant expanded protections in Costa Rican waters —
A three week expedition off the coast of Costa Rica has just expanded our knowledge of deep sea ecosystems in the region. Led...
Research: Earth’s magnetic shield booms like a drum when hit by impulses —
The Earth's magnetic shield booms like a drum when it is hit by strong impulses, according to new research from Queen Mary University...
Research: Discovery of the oldest evidence of mobility on Earth —
An international and multi-disciplinary team coordinated by Abderrazak El Albani at the Institut de chimie des milieux et matériaux de Poitiers (CNRS/Université de...
Research: The new genus is found exclusively in the recently recognized Seasonally Dry Tropical...
A new species of the Brazil-endemic small genus Mcvaughia is described as part of a extended revision of this unique group. The study...
Research: Toward automated animal identification in wildlife research —
A new automated method to prepare digital photos for analysis will help wildlife researchers who depend on photographs to identify individual animals by...
Research: Research team clarifies the mechanism of gliotoxin, a mycotoxin from the fungus Aspergillus...
It is everywhere -- and it is extremely dangerous for people with a weakened immune system. The fungus Aspergillus fumigatus occurs virtually everywhere...
Research: Where is the globally invasive noble false widow settling next? —
Spiders are one of the most successful groups of 'invaders' on the planet. Out of over 47,000 species of spiders known today, there...
Research: Sand from glacial melt could be Greenland’s economic salvation —
As climate change melts Greenland's glaciers and deposits more river sediment on its shores, an international group of researchers has identified one unforeseen...
Research: Zoology researchers solve mystery of how sea snakes quench their thirst —
Surrounded by salty water, sea snakes sometimes live a thirsty existence. Previously, scientists thought that they were able to drink seawater, but recent...
Top News
Hey ISIS, You Suck: Local Muslims Post Anti-ISIS Billboard
A new billboard on Manchester Road in Missouri reads, "HEY ISIS, YOU SUCK!!! From: #ActualMuslims."
A group of Muslim-Americans have put up a blunt billboard...